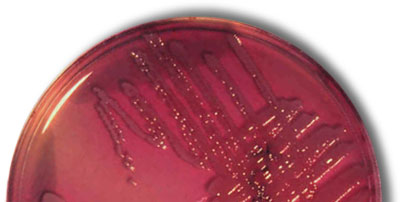

![]() |
|
E. coli Autor: Dr Alan Cann |
Etiología
Escherichia coli es una enterobacteria que forma parte de la microbiota normal del intestino de los animales sanos. La mayor parte de los E. coli presentes en un animal son cepas comensales y apatógenas e incluso tienen un papel beneficioso, ya que compiten de diversas formas con las cepas patógenas en el nicho ecológico de la luz intestinal.
El término E. coli engloba alrededor de 200 serotipos diferentes que se clasifican por sus antígenos de la pared celular (antígenos O), de la cápsula (antígenos K), de las fimbrias (antígenos F) y de los flagelos (antígenos H).
La tipificación de E. coli con métodos clásicos se está sustituyendo cada vez más por técnicas de epidemiología molecular como la electroforesis en campo pulsado (PFGE) o el análisis del número variable de repeticiones en tándem (VNTR) que permiten conocer con mayor exactitud la epidemiología de las enfermedades que causa esta enterobacteria.
Una de las características principales de E. coli es su gran capacidad de adaptarse a las condiciones ambientales y de experimentar cambios. Por ello, adquiere resistencia a los antibióticos con mucha mayor facilidad que otras bacterias.


Patogenia
Dentro de la capacidad adaptativa de E. coli está la posibilidad que tiene de utilizar numerosos factores de virulencia que explican la patogenia de las enfermedades que pueden causar las cepas patógenas. Estos factores de virulencia permiten a las cepas patógenas colonizar el intestino y competir en condiciones ventajosas con otras bacterias o con las cepas beneficiosas de E. coli.
Algunos de estos factores de virulencia no tienen importancia en las diarreas de los lechones lactantes. Por ejemplo, la producción de toxinas Shiga es el factor determinante de la enfermedad de los edemas que se manifiesta principalmente tras el destete.
Entre los factores de virulencia principales en la patogenia de las diarreas en lactantes destacan los antígenos fimbriales, que son adhesinas que permiten a E. coli fijarse a la pared intestinal y multiplicarse masivamente, y la producción de enterotoxinas.
Los factores de virulencia que poseen las cepas de E. coli permiten clasificar a éstas en “patotipos” que indican qué factores poseen estas cepas y explican la patogenia de las enfermedades que causan.
Dentro de estos patotipos, el más importante en las diarreas en lechones lactantes son el E. coli enterotoxigénico (ETEC) aunque el patotipo E. coli enteropatógeno (EPEC), también llamado E. coli de “adhesión y borrado”, (attaching and effacing E. coli o AEEC) puede también intervenir con mucha menor incidencia.
Escherichia coli enterotoxigénico (ETEC)
Las cepas de E. coli enterotoxigénico tienen como factores de virulencia principales las adhesinas. Las principales adhesinas se denominan actualmente F4, F5, F6, F41 y F18 (las tres primeras son las antes denominadas K88, K99 y 987P respectivamente). Estas adhesinas son inmunógenas y, por tanto, un componente fundamental de las vacunas. La F18 solo se ha encontrado asociada a diarreas en lechones destetados, por lo que no es necesaria su presencia en vacunas de cerdas que buscan la protección calostral de los lechones lactantes. Por otra parte, el antígeno fimbrial F41 frecuentemente se encuentra en cepas de E. coli que también contienen el antígeno F5 (K99).
Además de las adhesinas fimbriales, algunas cepas pueden producir otra adhesina denominada AIDA e implicada en una adherencia difusa.
Hay que considerar que E. coli evoluciona en función de la presión de selección que recibe. Por ejemplo, en una población vacunada contra F4(K88), E. coli no puede fijarse a la pared del intestino mediante esta adhesina, pero puede expresar otras que le permitan hacerlo y así multiplicarse con mayor facilidad. Por ello, las vacunas han ido incorporando (y deben seguir haciéndolo en el futuro) las nuevas adhesinas que vayan apareciendo en las cepas aisladas de casos clínicos para mantener su eficacia.
Como indicábamos, además de las adhesinas, otro factor de virulencia importante en las diarreas en lechones lactantes son las toxinas.
![]() |
|
PCR para las toxinas Sta, Stb, Lt Autor: Jean Le Guennec |
Las cepas enterotoxigénicas de E. coli producen dos enterotoxinas principales, una de ellas sensible al calor (LT) y la otra resistente al calor (ST). La toxina LT se divide en dos subgrupos denominados LTI y LTII. Los aislados porcinos producen LTI. La toxina ST se ha dividido en STa y STb en base a su solubilidad en metanol y a su actividad biológica.
Recientemente se ha encontrado una tercera toxina enteroagregativa y estable al calor denominada EAST1, cuyo papel en la diarrea de los lechones aún no está demostrado, aunque parece tener un mecanismo patogénico similar al de la toxina STa.
La LT es una toxina de alto peso molecular e induce fácilmente la formación de anticuerpos específicos, por lo que es un componente importante de las vacunas. La toxina actúa sobre los enterocitos activando la adenilatociclasa que estimula la producción de AMP cíclico, lo que provoca un aumento de la secrección de iones Cl-, Na+ y HCO3- y, en consecuencia, una diarrea por hipersecreción que provoca deshidratación, acidosis y, en casos graves, la muerte. Las heces de los lechones afectados tienen un pH alcalino.
![]() |
|
Heces líquidas con pH alcalino Autor: Jesús Bollo |
Las termoestables STa y STb son proteínas pequeñas y, por tanto, no inmunógenas. La STactiva la guanilatociclasa que estimula la producción de GMP cíclico y éste inhibe el sistema de cotransporte de Na/Cl en el intestino y reduce la absorción de electrolitos y agua causando también diarrea. La STa es activa en lechones menores de dos semanas de edad siendo menos activa en lechones de más edad, lo que probablemente se debe a que los cambios que se producen en la maduración intestinal inducen también diferencias en la concentración de los receptores a los que se une la toxina. La STb estimula la secreción de fluidos en el intestino independientemente de los nucleótidos cíclicos y probablemente de una forma mediada por prostaglandinas. La STb es sensible a la tripsina y, por tanto, tiene mayor actividad en los lechones que están tomando calostro.
Hasta hace unos años, las cepas más comunes de E. coli enterotoxigénico aisladas de casos de diarrea en lactantes pertenecían a los serogrupos O8, O147, O148 y O157, poseían la fimbria F4(K88) y producían las toxinas LTI y STb. Recientemente se ha incrementado el aislamiento de cepas de otros serogrupos (O8, O9, O64…) que tienen todos o alguno de los antígenos fimbriales F5(K99), F6(987P) y F41 y que principalmente producen la toxina STa y en menor grado la STb. Estas cepas causan diarrea sobre todo en lechones menores de una semana de edad mientras que las cepas productoras de F4(K88) afectan a lechones de cualquier edad, desde el nacimiento hasta después del destete.
Escherichia coli enteropatógeno (EPEC)
Las cepas de E. coli de este patotipo se denominan también, como indicábamos, de adhesión y borrado (attaching and effacing o AEEC) porque causan enfermedad uniéndose a los enterocitos de la mucosa intestinal mediante una proteína de la membrana externa denominada “intimina” o Eae (“Enterotoxigenic E: coli attaching and effacing factor”) destruyendo las microvellosidades e invadiendo las células. El “borrado” de las microvellosidades hace que disminuya considerablemente la superficie de los enterocitos en el intestino y por tanto se altera tanto la digestión de nutrientes como la absorción de éstos, así como la absorción de fluidos y de electrolitos.
Las cepas EPEC se han asociado con mayor frecuencia a diarreas postdestete, pero pueden intervenir también en las diarreas en lactación.
Cuadro clínico y lesional
En algunos casos, las cepas de E. coli son tan agresivas que los lechones mueren sin haber tenido diarrea, que es el principal signo clínico. Esta diarrea tiene una gravedad variable en función de los factores de virulencia de la cepa implicada, de la edad del lechón y de su estado inmunitario. Puede ser más o menos acuosa y el color de las heces también es muy variable. Las heces no suelen manchar mucho el periné de los lechones y a veces solo se observa en éstos irritación en la zona perianal sin restos de heces.
![]() |
|
Zona perianal irritada y diarrea Autor: B&M cvp |
![]() |
|
Camada entera afectada Autor: Jesús Bollo |
La diarrea por hipersecreción provoca una deshidratación que puede hacer que el lechón pierda hasta el 40 % del peso y, al avanzar, conduce a una acidosis metabólica.
En las condiciones adecuadas, la diarrea puede aparecer ya en las primeras horas tras el nacimiento afectando bien a lechones aislados o bien a camadas enteras. Las camadas de las cerdas primerizas están, en general, más afectadas así como los lechones de menor peso de cada camada, que son los que toman menos calostro y los que tienen una lactación de menor calidad.
En algunos casos puede haber también vómitos. Los lechones están deprimidos, con el abdomen fláccido y hundido, el pelo en mal estado y con un color grisáceo.
![]() |
|
Los lechones de menor peso son los más afectados Autor: Jesús Bollo |
La prevalencia es muy variable en función de la calidad de las instalaciones, de la inmunidad de las cerdas y de la virulencia de las cepas. La gravedad de la diarrea disminuye a medida que aumenta la edad de los lechones y la mortalidad también es muy variable, pero puede ser muy elevada especialmente en lechones de pocos días de edad hijos de cerdas sin inmunidad y cuando se retrasa el tratamiento.
No hay lesiones muy específicas. Macroscópicamente hay deshidratación, el estómago suele estar lleno de leche sin digerir y el intestino delgado está distendido y congestivo.
![]() |
|
Aspecto del intestino de un lechón con diarrea colibacilar Autor: B&M cvp |
Diagnóstico

El cuadro clínico y la alcalinidad de las heces son orientativos, pero el diagnóstico debe confirmarse en el laboratorio aislando e identificando las cepas y sus factores de virulencia.
![]() Cultivo de E. coli |
Tratamiento y profilaxis
La rapidez del tratamiento es esencial para que sea lo más eficaz posible. Hay muchos antibióticos que, teóricamente, pueden tener una buena eficacia contra E. coli, pero también son muy frecuentes las resistencias. Por ello, es conveniente realizar en cada granja antibiogramas periódicos que permitirán elegir los antibióticos más eficaces. En general, algunas quinolonas y cefalosporinas tienen una buena actividad.
Los tratamientos pierden eficacia en muchas ocasiones porque no se utiliza la dosis adecuada del antibiótico, no se administra con el intervalo de tiempo necesario o el tratamiento no tiene la duración suficiente. Estos errores además contribuyen notablemente a que aparezcan resistencias.
La administración por vía oral o intraperitoneal de fluidos con glucosa y electrolitos contribuye a paliar la deshidratación y la acidosis y el empleo de probióticos ayuda a la recuperación de los lechones afectados.
En la profilaxis son fundamentales las condiciones ambientales. Las salas de parto limpias y con las condiciones adecuadas de temperatura ambiental y temperatura del nido, ventilación, etc. tienen en general menos problemas de colibacilosis.
En la profilaxis también es capital todo aquello que interviene en que los lechones tengan un encalostramiento correcto y una lactación de la mejor calidad posible. La agalaxia o hipogalaxia de las cerdas son un factor desencadenante de toda clase de problemas en los lechones y, entre ellos, de las diarreas por E. coli. El diseño inadecuado de las jaulas de parto, la escasez de pezones, el enfriamiento de los lechones, la humedad, etc. también son factores predisponentes.
![]() |
| Un buen encalostramiento es esencial en la profilaxis de la colibacilosis |
La inmunidad en la colibacilosis de los lechones es humoral. En los primeros días de vida, el lechón depende de los anticuerpos que recibe del calostro de la cerda y posteriormente de la IgA secretora presente en la leche hasta que su sistema inmunitario tiene una capacidad de reacción suficiente. Por ello, como indicábamos, los fallos de la lactación son muy importantes.
La vacunación de las cerdas es una de las medidas más eficaces para prevenir la colibacilosis de los lechones lactantes. Las vacunas contra la colibacilosis de los lechones son de diverso tipo. En el mercado existen bacterinas que contienen cepas de los principales serogrupos O, antígenos fimbriales y enterotoxinas y otras son vacunas de subunidades que contienen antígenos fimbriales y enterotoxinas purificados.
La vacunación de las cerdas a las 6-8 semanas antes del parto y la revacunación 2-3 semanas antes del mismo induce una buena inmunidad lactogénica capaz de proteger adecuadamente al lechón durante las primeras semanas de vida, que es cuando es más receptivo.
![]() |
|
La calidad de las instalaciones determina en buena medida el impacto de la colibacilosis Autor: Jesús Bollo |
No obstante, la vacunación no puede sustituir a las medidas de alojamiento, manejo y lactación adecuadas.
En parideras sucias, húmedas y en malas condiciones la presión de infección puede superar a la inmunidad vacunal. Del mismo modo, cuando hay problemas de agalaxia o hipogalaxia en las cerdas, el lechón no recibe los anticuerpos generados en el calostro y en la leche o solo recibe una cantidad insuficiente y, por tanto, puede no estar bien protegido. En camadas largas o en camadas de primerizas, puede haber lechones que no mamen lo suficiente que serán los que padecerán la diarrea. El frío afecta notablemente a la vitalidad de los lechones y puede contribuir también a que éstos no mamen lo suficiente, siendo un factor coadyuvante importante de la diarrea colibacilar.
Cuando algunos lechones, por problemas de manejo, alojamiento o lactación, padecen diarrea aumentarán la presión de infección sobre los demás lechones de la camada y extenderán con facilidad el problema a toda ella.